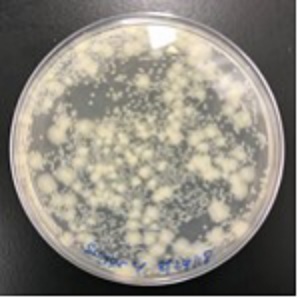

|
 |
 |
البكتيريا المعوية مفتاح تعارف نحل العسل
تاليا أوغليور
البكتيريا المعوية مفتاح تعارف نحل العسل
" أنا نحلة عسل ! " الدراسة: بكتيريا الأمعاء هي مفتاح تعارف النحل بقلم: تاليا أوغليور هل انت من تقول انا؟ النحل الحارس يفحص النحل الجاني عند مدخل الخلية.
بالنسبة إلى نحلة العسل ، هناك القليل من الأشياء الأكثر أهمية من التعرف على زملائك في العش. يمكن أن تعني القدرة على تمييز رفيق العش من الغازي الفرق بين خلية مليئة بالعسل وشتاء طويل فقير. أظهر بحث جديد من جامعة واشنطن في سانت لويس أن نحل العسل يعتمد على الإشارات الكيميائية المتعلقة بالمجتمعات الميكروبية في الأمعاء المشتركة ، بدلاً من الارتباط الجيني ، لتحديد أعضاء خلاياهم. بن شاحر قال يهودا بن شاهار ، أستاذ علم الأحياء في الآداب والعلوم والمؤلف المقابل للدراسة التي نُشرت في 14 أكتوبر في Science Advances ، "معظم الناس لا ينتبهون إلا إلى جينات النحل الفعلية". "ما نظهره هو أنها وراثية ، لكنها جينات البكتيريا." يتعرف نحل العسل ويستجيب للإشارات الكيميائية من النحل الآخر التي يكتشفها من مركبات الجلد المعروفة باسم الهيدروكربونات الجلدية أو CHCs. . حددت هذه الدراسة أن ملف CHC الخاص بالنحلة يعتمد على الميكروبيوم - البكتيريا التي تشكل مجتمع ميكروبيوم الأمعاء - وليس شيئًا فطريًا أو وراثيًا للنحلة وحدها. قالت كاسندرا إل فيرنير ، زميلة ما بعد الدكتوراه في جامعة إلينوي ، التي حصلت على درجة الدكتوراه في علم الأحياء مي جامعة واشنطن: "تحتوي الخلايا المختلفة في الواقع على ميكروبيومات خاصة بالخلايا، والتي لم تظهر من قبل". قال فيرنير ، المؤلف الأول للدراسة الجديدة: "يتشارك النحل الطعام مع بعضهم البعض باستمرار - ويتبادلون هذا الميكروبيوم داخل خلاياهم"
يشمل المؤلفون المشاركون غوتام دانتاس ، أستاذ علم الأمراض والمناعة وعلم الأحياء الدقيقة الجزيئي في كلية الطب بجامعة واشنطن في سانت لويس ، وجويل ليفين في جامعة تورونتو ميسيسوجا. تم إجراء العمل جزئيًا مع النحل الموجود في مركز أبحاث تايسون ، المحطة الميدانية البيئية لجامعة واشنطن. قال فيرنير: "تكمن أهمية هذه الورقة في أنها واحدة من الأوراق الأولى التي تظهر بالفعل أن الميكروبيوم متورط في البيولوجيا الاجتماعية الأساسية لنحل العسل - وليس فقط التأثير على صحتهم". "الميكروبيوم متورط في كيفية عمل الخلية ككل ، وكيف أنها قادرة على الحفاظ على دفاعات العش ، بدلاً من مجرد الدفاع المناعي داخل الفرد." يؤثر الميكروبيوم على التواصل يزود المجتمع الميكروبي المعوي - أو الميكروبيوم - البشر والحيوانات الأخرى بالفيتامينات ، ويساعد على هضم الطعام ، وينظم الالتهاب ويحافظ على الميكروبات المسببة للأمراض تحت السيطرة. على نحو متزايد ، أصبح موضوع اهتمام البحث ، اكتشف العلماء العديد من الطرق التي يطمس بها الميكروبيوم الحدود بين المضيف والبكتيريا.
" المؤلف الأول Vernier يرعى النحل. (الصورة: كاتلين ماركوس) وجد أن الميكروبيوم يؤثر على التواصل في العديد من الكائنات الحية المختلفة - بما في ذلك ، على وجه الخصوص ، الحيوانات الكبيرة مثل الضباع. بالنسبة لنحل العسل ، تُظهر هذه الدراسة أن الميكروبيوم يلعب دورًا مهمًا في تحديد الإشارات الكيميائية المنظمة بإحكام لعضوية المجموعة. حتى وقت قريب ، اعتقد معظم العلماء أن نحل العسل يتعرف على زملائه في العش من خلال التقاط رائحة متجانسة يتعرفون عليها من أعضاء خلاياهم - "نوع من خلية النحل" ، كما قال بن شاهار مازحا. تتكون خلايا النحل عادة من أفراد ذوي صلة وثيقة. لكن الإشارات الكيميائية التي تسمح للنحل بالتعرف على بعضها البعض لا تحددها الجينات وحدها. يعرف الباحثون ذلك لأنه يمكن وضع صغار النحل في خلايا أخرى دون أن يتم رفضها - حتى سن ومستوى معين من التطور. قال فيرنير: "يجب أن يكون شيئًا يكتسبونه خلال حياتهم هو الذي يحدد إشارات التعرف على زملائهم في العش". مكتسبة من التفاعلات مع النحل الآخر في العمل السابق ، أظهر Vernier و Ben-Shahar أن النحل يطور سمات رائحة مختلفة مع تقدمهم في العمر ، وأن النحل البواب يستجيب بشكل مختلف للباحثين الذين يعودون إلى الخلية مقارنة بالنحل الأصغر الذي لم يغامر بالخارج. قصة ذات صلة: كسب أجنحة نحلة أسس هذا البحث علاقة بين التعرف على رفقاء العش وتقسيم العمل المحدد بوضوح والمعتمد على العمر النموذجي لخلايا نحل العسل. فقط عندما تكون النحلة كبيرة بما يكفي للتفاعل مع الآخرين خارج الخلية ، يصبح من السهل التعرف عليها من قبل الآخرين. كان هذا دليلًا للباحثين. قال فيرنير: "إذا قمت بزراعة نحلة عسل بمعزل عن غيرها ، فلن تتطور أبدًا إلى ميكروبيوم كامل". "في الواقع يجب أن يكتسب معظمه "الميكروبيوم" من التفاعلات مع النحل الآخر."
في هذه الدراسة ، قرر الباحثون أن النحل الجاني في خلايا نحل العسل المختلفة لديه مجتمعات ميكروبية مختلفة في الأمعاء وملامح CHC من خلال تسلسل عينات الأمعاء وتحليل المستخلصات الجلدية. أجرى العلماء أيضًا تجارب رعاية عبر الخلية ، حيث قاموا بتربية مجموعات من النحل حديث التفقيس في خلاياهم الخاصة أو الخلايا غير ذات صلة. في تجارب التعزيز ، وجد الباحثون أن العوامل المرتبطة بالمصدر والخلية المضيفة تساهم في الاختلافات في المجتمع الميكروبي المعوي الكلي للنحل الفردي. من بين 14 نوعًا ميكروبيًا تختلف اختلافًا كبيرًا بينها، كانت ستة أنواع متشابهة بين النحل الذي شارك في نفس بيئة الخلية أثناء نشأته - بغض النظر عن الارتباط الجيني الفعلي. وجد الباحثون أيضًا أنه يمكنهم التلاعب بالميكروبيوم الخاص بالنحل الشقيق عن طريق تغذية ميكروبات مختلفة للنحل الذي فقس حديثًا. بالإضافة إلى تطوير مجتمعات جرثومية مختلفة في الأمعاء ، نما النحل أيضًا ليكون لديه ملفات تعريف CHC مختلفة. قال فيرنير: "لم يكن من الممكن التعرف عليهم من قبل أشقائهم". "كان التلاعب بالميكروبيوم كافيًا لجعل النحل الشقيق يطور سماة رائحة مختلفة." الأنواع الصحيحة قال الباحثون إن هذا العمل الجديد مهم جزئيًا لأنه يُظهر دورًا أساسيًا للميكروبيوم في التفاعلات الاجتماعية اليومية الأساسية لنحل العسل ، أهم ملقحات الأرض. "بالنسبة للنحل ، تعتمد بعض الجوانب الأكثر تعقيدًا في سلوكهم الاجتماعي أساسًا على البكتيريا - أكثر من أي شيء آخر!" قال بن شاهار. قال: "لا يهم مدى ارتباطهم". تعتمد قدرتهم على قول "إنك تنتمي إلى هذه المجموعة" أساسًا على الحصول على البكتيريا المناسبة في الوقت المناسب. وإلا فهم عميان عن ذلك. " معرف النحل هو المفتاح. أكبر عدو لنحل العسل هو النحل الآخر.
قال فيرنير: "خلال الخريف ، عندما تتوقف النباتات عن إنتاج الرحيق ، هناك فترة من الوقت تكون فيها السرقة منتشرة جدًا في الخلايا. "سيجد النحل المسروق الخلايا أخرى ، وإذا تمكنوا من الدخول وأخذ بعض العسل ، فسيعودون إلى أعشاشهم ويشيرون: مرحبًا ، اذهب إلى هناك. هناك عش ليس جيدًا في حراسته ، ويمكننا سرقة عسلهم." قالت "النحل السارق سيأخذ هذا العسل ويترك الخلية الأخرى لتموت جوعا". "إنه ضغط قوي للغاية." قال الباحثون إن السرقة تحرم كلاً من النحل المضيف والبكتيريا المرتبطة به من موارد مهمة - والتي ربما كانت الدافع الأصلي لتشكيل هذه الشراكة الخاصة بين البكتيريا والحيوان. 15 أكتوبر 2020
تاليا أوغليور
|